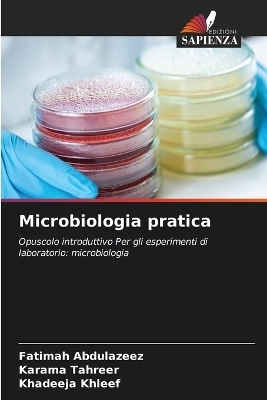
Microbiologia pratica - Fatimah Abdulazeez, Karama Tahreer, Khadeeja Khleef

Microbiologia pratica
Seiten
2025
Edizioni Sapienza (Verlag)
978-620-8-76754-9 (ISBN)
Edizioni Sapienza (Verlag)
978-620-8-76754-9 (ISBN)
- Titel nicht im Sortiment
- Artikel merken
| Erscheinungsdatum | 24.03.2025 |
|---|---|
| Sprache | italienisch |
| Maße | 152 x 229 mm |
| Gewicht | 95 g |
| Themenwelt | Naturwissenschaften ► Biologie ► Allgemeines / Lexika |
| Naturwissenschaften ► Biologie ► Mikrobiologie / Immunologie | |
| Schlagworte | Bacteria • batteri • biochemical test • micologia • Mycology • stafilococco • staphyllococcus • test biochimici • Virus |
| ISBN-10 | 620-8-76754-7 / 6208767547 |
| ISBN-13 | 978-620-8-76754-9 / 9786208767549 |
| Zustand | Neuware |
| Informationen gemäß Produktsicherheitsverordnung (GPSR) | |
| Haben Sie eine Frage zum Produkt? |
Mehr entdecken
aus dem Bereich
aus dem Bereich
Buch | Softcover (2024)
Wiley-VCH (Verlag)
CHF 55,85
Band 2: Elektrizität, Optik und Wellen
Buch | Softcover (2022)
Wiley-VCH (Verlag)
CHF 55,85
Vom Ursprung der Sexualitat zum modernen Menschen
Buch | Softcover (2025)
UTB (Verlag)
CHF 54,60


